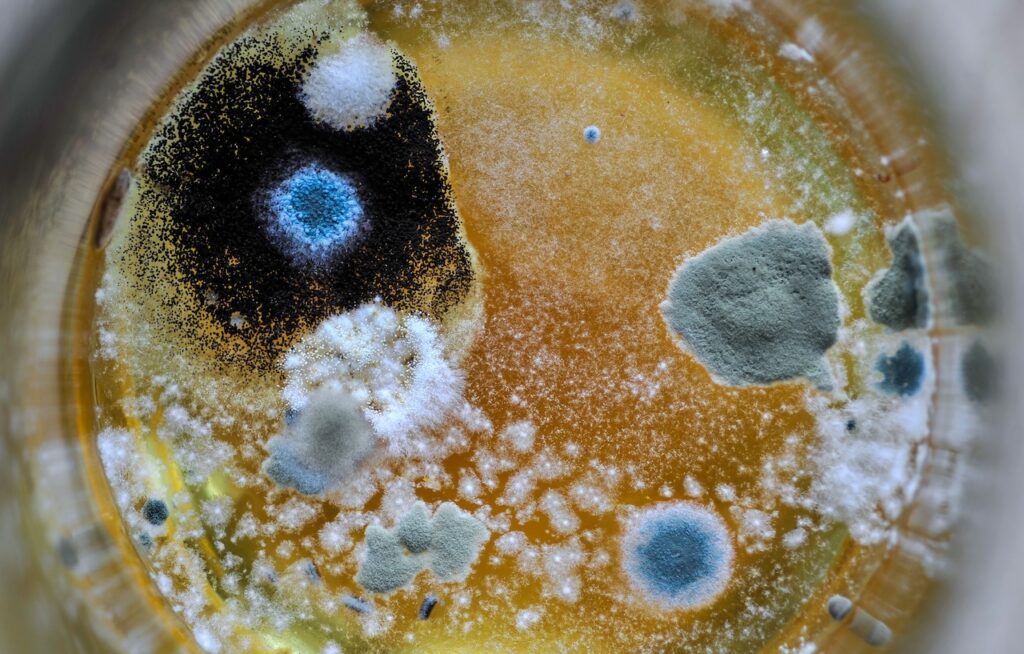

Table of Contents
Black Mold vs Regular Mold
Mold is a common household issue that can lead to serious health risks and structural damage. While molds should be addressed quickly, not all types are identical. Understanding the key differences between black mold vs regular mold is crucial for effective treatment and prevention. In this blog, we’ll explore the health risks, visual differences, treatment options, and preventive measures to help keep your home mold-free.
Health Risks: Black Mold vs Regular Mold

Black mold can pose more serious health threats than regular mold.
One of the main concerns with mold growth is its potential health risks. While most types of mold can cause respiratory issues and allergic reactions, black mold (Stachybotrys chartarum) is known for its more severe health effects. Black mold releases mycotoxins, which can cause chronic respiratory problems, fatigue, headaches, and, in extreme cases, damage the central nervous system. Those with compromised immune systems or asthma are particularly vulnerable to black mold exposure.
In contrast, regular mold—which includes varieties such as Aspergillus, Cladosporium, and Penicillium—can still cause allergic reactions, including coughing, sneezing, itchy eyes, and skin rashes. However, regular mold is typically less dangerous than black mold, though prolonged exposure to any mold can still have adverse effects.
Visual Differences: Black Mold vs Regular Mold
Identifying the type of mold you’re dealing with can help determine the level of threat and the necessary response.
- Black mold often appears as dark green or black patches and thrives in areas with constant moisture, such as bathrooms, basements, and leaky pipes. It has a slimy texture and tends to grow on materials with high cellulose content, like wood, drywall, and paper.
- Regular mold tends to come in various colors, including white, yellow, green, and blue. While it can grow in damp areas like black mold, regular mold is often found on food, fabrics, and other household surfaces. Its texture can range from powdery to fuzzy.
It’s important to remember that even regular mold can spread quickly and cause damage to your home, so prompt treatment is necessary.
Regular mold will appear more powdery or fuzzy and can be found in various colors.
Treatment Options: Black Mold vs Regular Mold
Treating black and regular mold requires different approaches, but in both cases, prompt action is essential to prevent the spread and minimize health risks.
- Black mold treatment: Due to its toxicity, black mold often requires professional remediation. Cleaning black mold without the right safety gear can expose you to harmful mycotoxins. If you notice black mold in your home, it’s best to contact professionals like us, who have the proper equipment and training to remove it safely.
- Regular mold treatment: Small areas of regular mold can often be cleaned with household products like vinegar or hydrogen peroxide. However, larger infestations may require professional assistance to ensure complete removal and prevent recurrence. Proper ventilation and moisture control are key to preventing regular mold from returning.
Quick Comparison: Black Mold vs Regular Mold
| Feature | Black Mold (Stachybotrys) | Regular Mold (Common Varieties) |
|---|---|---|
| Color & Texture | Dark green or black, slimy texture | White, yellow, green, or blue; often fuzzy or powdery |
| Common Locations | Areas with chronic moisture—basements, drywall, HVAC systems | Bathrooms, kitchens, fabrics, food, and windowsills |
| Health Risks | Can produce mycotoxins; linked to respiratory issues, headaches, fatigue | Causes allergies and irritation; usually less toxic |
| Odor | Strong, musty, earthy smell | Musty or damp odor, usually milder |
| Treatment | Requires professional mold remediation | Small spots may be cleaned safely with home methods |
| Risk Level | High—should always be handled by experts | Moderate—still needs prompt attention |

Regular mold can generally be tackled with commercial or homemade cleaners.
Preventive Measures to Avoid Mold Growth
Prevention is the best course of action, whether you’re dealing with black or regular mold. Here are some essential steps you can take to minimize mold growth in your home:
- Control moisture levels: Mold thrives in damp environments. Use dehumidifiers in high-humidity areas like basements and bathrooms, and ensure your home is well-ventilated.
- Fix leaks promptly: Whether it’s a dripping faucet or a leaking roof, moisture from leaks can create the perfect breeding ground for mold. Address plumbing or structural issues quickly to prevent mold from taking hold.
- Regular cleaning: Clean and disinfect moisture-prone areas, such as bathrooms, kitchens, and basements. Regular maintenance can prevent minor mold issues from growing into bigger problems.
- Monitor indoor humidity: To prevent mold from developing, keep indoor humidity levels below 60%. You can use a hygrometer to measure humidity levels in different areas of your home.
Contact us for Professional Mold Remediation Services
Whether you’re facing black mold or regular mold, both can compromise your home’s air quality, structure, and your family’s well-being. The key difference lies in black mold’s toxicity—it requires expert removal to prevent serious health problems.
If you suspect mold in your Columbus home, don’t wait. PuroClean Fire & Water Experts provides certified, safe, and fast mold remediation backed by industry-leading equipment and local expertise.
Call (614) 309-5739 today or visit our website to schedule a mold inspection or emergency remediation service.
Frequently Asked Questions
1. Is black mold always toxic?
Not all dark molds are toxic, but Stachybotrys chartarum—the common “black mold”—can release harmful mycotoxins, especially in damp indoor environments.
2. Can I clean mold myself?
You can safely clean small patches of regular mold, but black mold should only be handled by certified professionals due to health risks.
3. What does black mold smell like?
Black mold often has a strong, earthy odor—much more pungent than regular mold.
4. Does insurance cover mold removal?
Policies may cover mold resulting from sudden water damage (like burst pipes), but not from long-term leaks or neglect. Check your specific coverage.
5. How can I tell if mold has spread behind walls?
Persistent odors, bubbling paint, or soft drywall are strong signs of hidden mold growth. A professional moisture inspection can confirm it.
Summary
- Columbus experts: PuroClean offers 24/7 mold remediation and moisture control services.
- Black mold vs regular mold: Black mold is more toxic and needs professional removal.
- Common signs: Musty odor, dark spots, or allergies.
- Prevention: Control humidity, fix leaks, and ventilate properly.
Explore more helpful articles:





